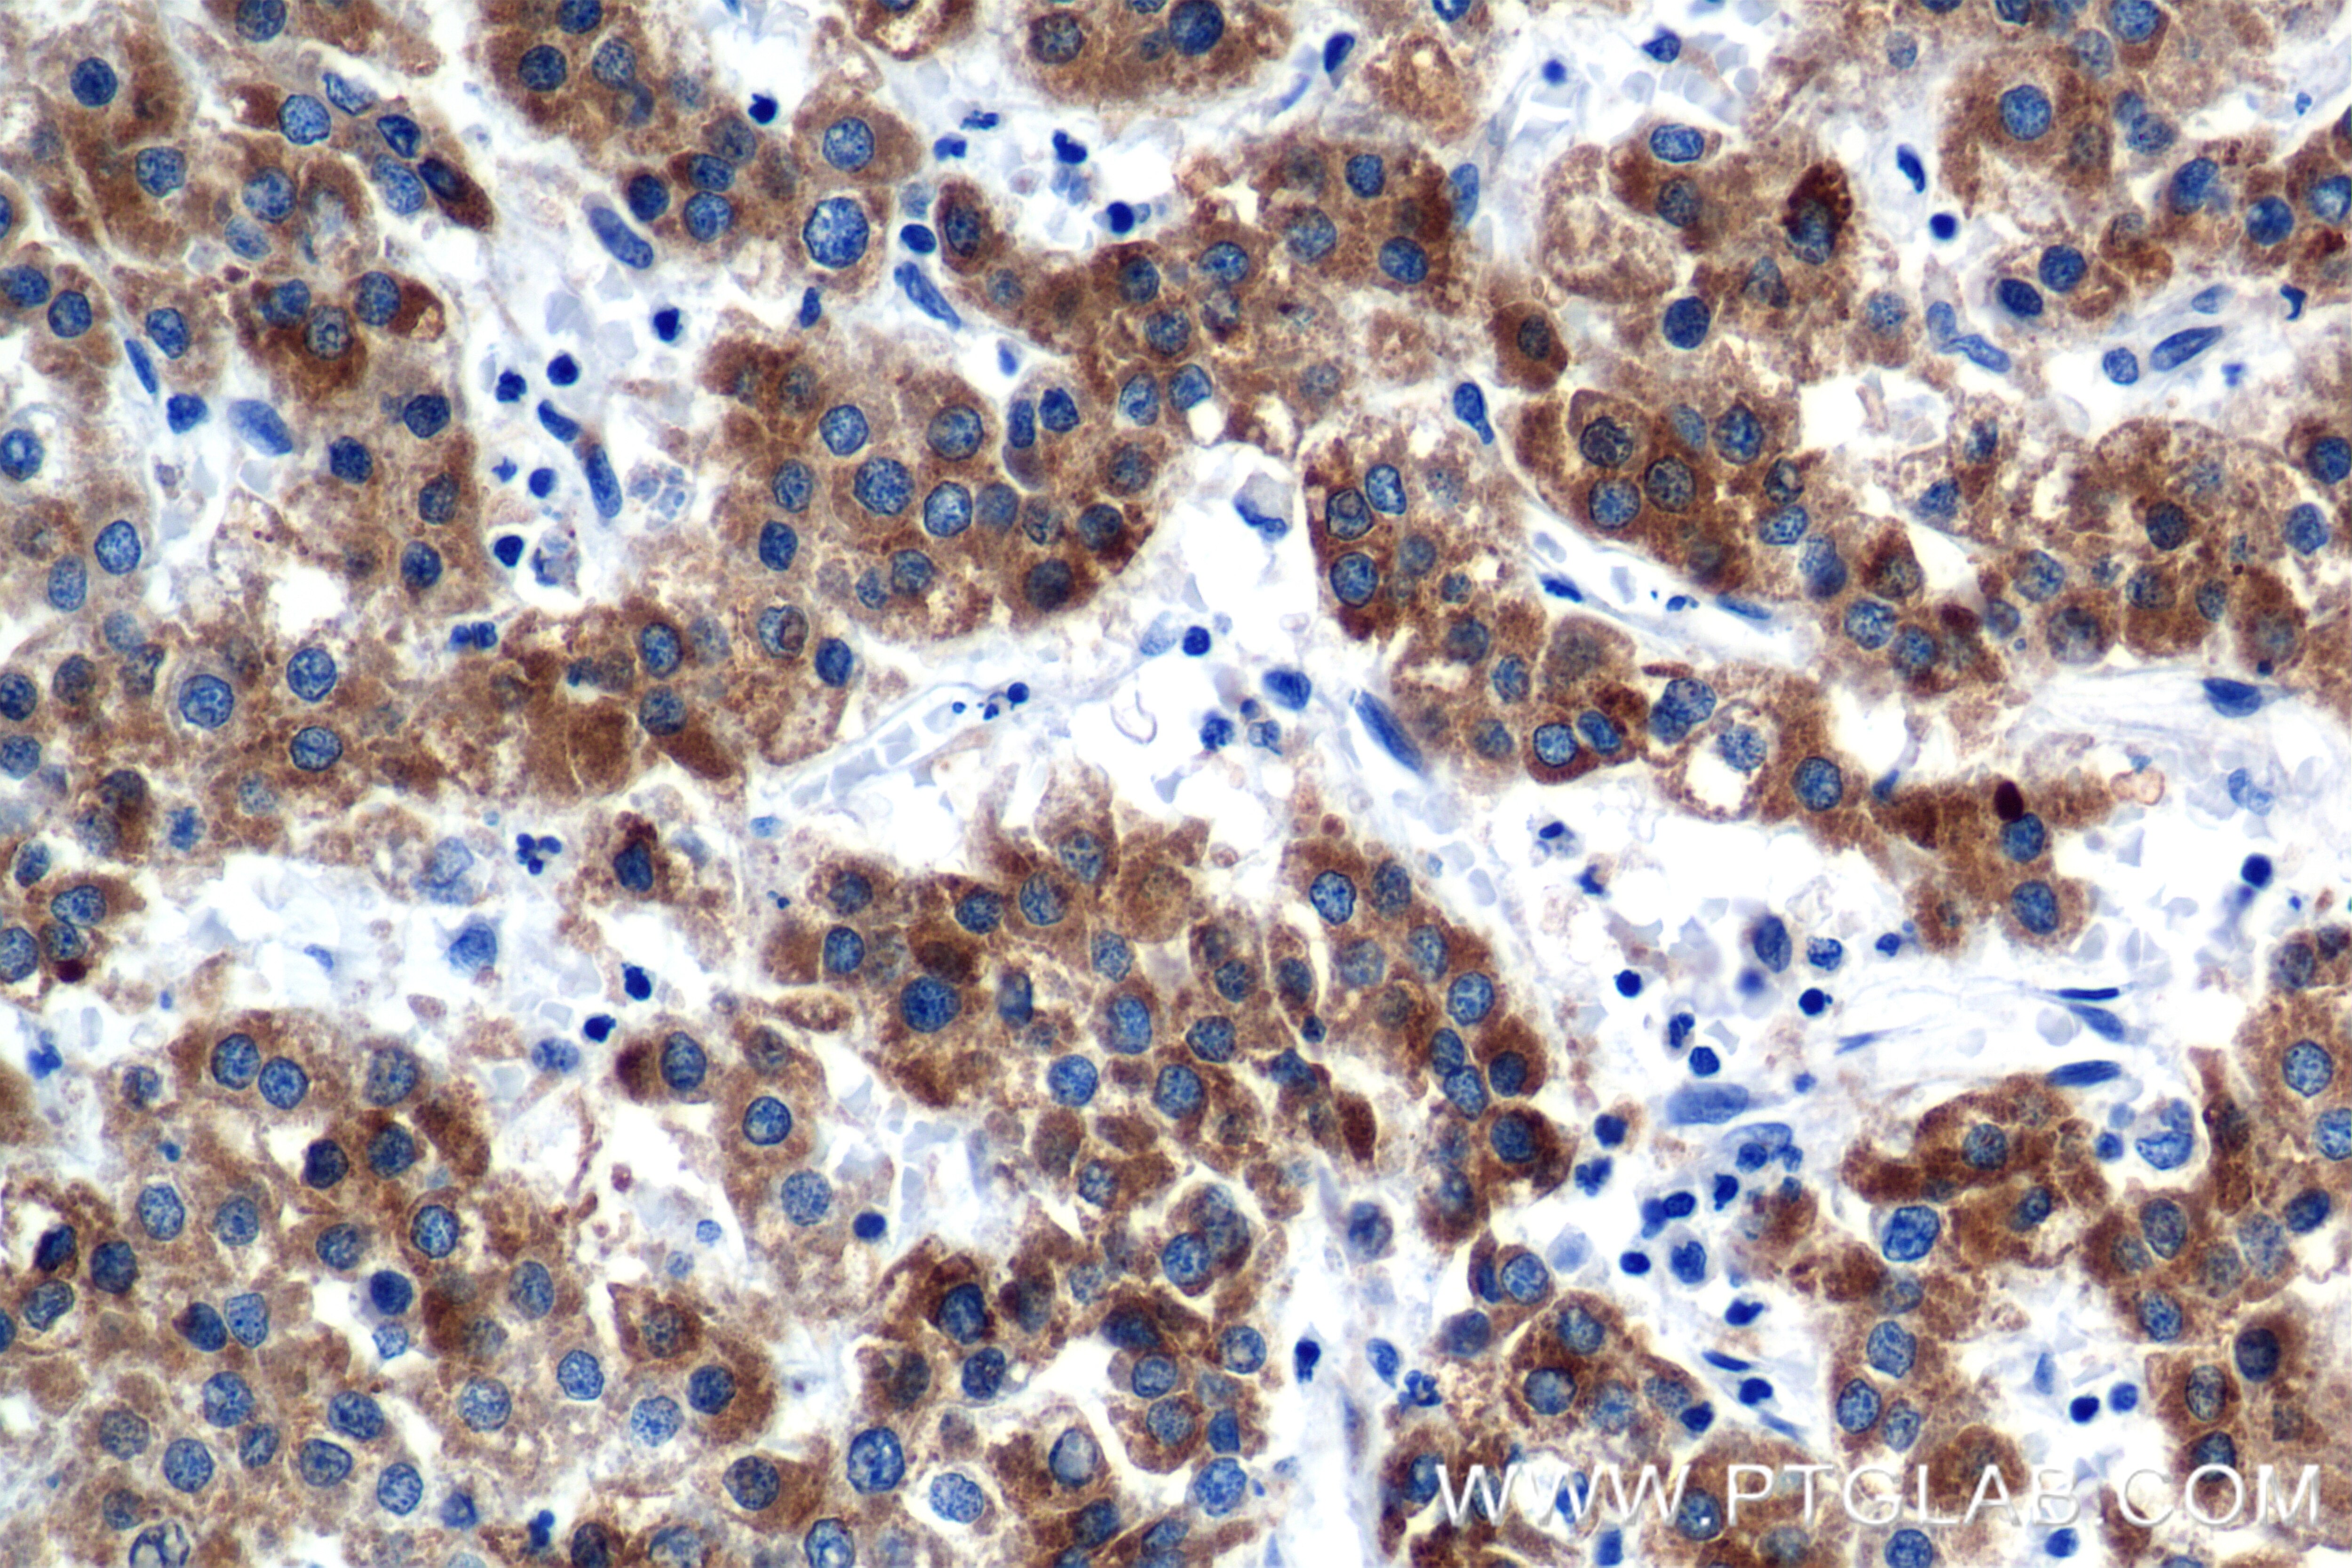
Immunohistochemical analysis of paraffin-embedded Human Hepatocellular cancer slide using 84751-1-RR (CYP1A2-Specific antibody) at dilution of 1:400 (under 40x lens). Heat mediated antigen retrieval with Tris-EDTA buffer (pH 9.0). Immunohistochemistry (IHC) staining of Human Hepatocellular cancer using CYP1A2-Specific Recombinant monoclonal antibody (84751-1-RR)

Validation Data Gallery
Tested Applications
| Positive WB detected in | HepG2 cells, HEK-293 cells |
| Positive IHC detected in | Human Hepatocellular cancer tissue, mouse liver tissue Note: suggested antigen retrieval with TE buffer pH 9.0; (*) Alternatively, antigen retrieval may be performed with citrate buffer pH 6.0 |
Recommended dilution
| Application | Dilution |
|---|---|
| Western Blot (WB) | WB : 1:500-1:2000 |
| Immunohistochemistry (IHC) | IHC : 1:200-1:800 |
| It is recommended that this reagent should be titrated in each testing system to obtain optimal results. | |
| Sample-dependent, Check data in validation data gallery. | |
Product Information
84751-1-RR targets CYP1A2-Specific in WB, IHC, ELISA applications and shows reactivity with human, mouse samples.
| Tested Reactivity | human, mouse |
| Host / Isotype | Rabbit / IgG |
| Class | Recombinant |
| Type | Antibody |
| Immunogen |
Peptide 相同性解析による交差性が予測される生物種 |
| Full Name | cytochrome P450, family 1, subfamily A, polypeptide 2 |
| Calculated molecular weight | 58 kDa |
| Observed molecular weight | 58 kDa |
| GenBank accession number | NM_000761 |
| Gene Symbol | CYP1A2 |
| Gene ID (NCBI) | 1544 |
| RRID | AB_3672134 |
| Conjugate | Unconjugated |
| Form | |
| Form | Liquid |
| Purification Method | Protein A purfication |
| UNIPROT ID | P05177 |
| Storage Buffer | PBS with 0.02% sodium azide and 50% glycerol{{ptg:BufferTemp}}7.3 |
| Storage Conditions | Store at -20°C. Stable for one year after shipment. Aliquoting is unnecessary for -20oC storage. |
Background Information
CYP1A2, also named as CP12; P3-450 and P450(PA), belongs to the cytochrome P450 family. Cytochromes P450 are a group of heme-thiolate monooxygenases. In liver microsomes, CYP1A2 is involved in an NADPH-dependent electron transport pathway. It oxidizes a variety of structurally unrelated compounds, including steroids, fatty acids, and xenobiotics. Most active of CYP1A2 is in catalyzing 2-hydroxylation. Caffeine is metabolized primarily by cytochrome CYP1A2 in the liver through an initial N3-demethylation. It also acts in the metabolism of aflatoxin B1 and acetaminophen. CYP1A2 participates in the bioactivation of carcinogenic aromatic and heterocyclic amines. It catalizes the reaction: RH + reduced flavoprotein + O2 = ROH + oxidized flavoprotein + H2O. The antibody is specific to CYP1A2.
Protocols
| Product Specific Protocols | |
|---|---|
| IHC protocol for CYP1A2-Specific antibody 84751-1-RR | Download protocol |
| WB protocol for CYP1A2-Specific antibody 84751-1-RR | Download protocol |
| Standard Protocols | |
|---|---|
| Click here to view our Standard Protocols |